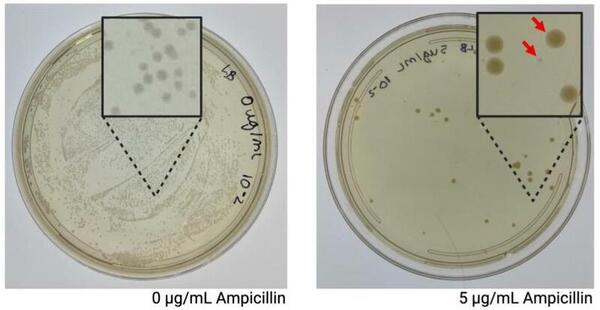
Investigating facilitated biofilm formation in <em>Escherichia coli</em> exposed to sublethal levels of ampicillin

Here, the researchers investigated how exposure to active versus passive music affects a teenager's ability to perform a challenging task, namely a Sudoku puzzle, under stressful conditions. Following testing 75 high school teenagers split into two group, the researchers found that singing in a choir (active music) yielded a greater improvement in performance compared to passive listening for brief time periods.
Read More...

.jpeg)

